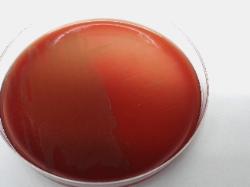

| S. cristatus Gram-positive cells grouped in chains |
| Streptococcus cristatus colonies on sheep blood agar |
| Streptococcus cristatus |
May be involved in the establishment of periodontopathic plaque, in association with
other bacteria.
other bacteria.
Taxonomy
Morphology
Cultural characteristics
Biochemical characters
Ecology
Pathogenicity
References
Phylum Bacillota (Firmicutes), Class Bacilli, Order Lactobacillales, Family Streptococcaceae, Genus Streptococcus, Streptococcus
cristatus corrig. Handley et al. 1991.
Synonyms: Streptococcus crista Handley et al. 1991, Streptococcus oligofermentans Tong et al. 2003..
Admin note: S. cristatus NCTC 12479 strain reacted with Lancefield group F antiserum.
cristatus corrig. Handley et al. 1991.
Synonyms: Streptococcus crista Handley et al. 1991, Streptococcus oligofermentans Tong et al. 2003..
Admin note: S. cristatus NCTC 12479 strain reacted with Lancefield group F antiserum.
Gram-positive cocci, 1 µm in diameter, grouped in chains. Cells have tufts of fibrils in
a lateral position. Non-motile.
a lateral position. Non-motile.
Colonies grown at 37 ºC for 2 days on blood agar are greyish white, glossy, entire,
alpha-hemolytic, and 1 to 2 mm in diameter.
Glucan production on sucrose-containing medium is a variable characteristic.
Grow at 37 ºC in brain heart infusion broth supplemented with 0.3% (wt/vol) added
yeast extract or on blood agar with 5% defibrinated horse blood. Facultatively
anaerobic.
alpha-hemolytic, and 1 to 2 mm in diameter.
Glucan production on sucrose-containing medium is a variable characteristic.
Grow at 37 ºC in brain heart infusion broth supplemented with 0.3% (wt/vol) added
yeast extract or on blood agar with 5% defibrinated horse blood. Facultatively
anaerobic.
Isolated from human throats and oral cavities. Salivary alpha-amylase is bound.
- Handley P., Coykendall A., Beighton D., Hardie J.M. & Whiley R.A.: Streptococcus crista sp. nov., a viridans streptococcus with
tufted fibrils, isolated from the human oral cavity and throat. Int. J. Syst. Bacteriol., 1991, 41, 543-547. - Truper H.G. and De' Clari L): Taxonomic note: Necessary correction of specific epithets formed as substantives (nouns) "in
apposition". Int. J. Syst. Bacteriol., 1997, 47, 908-909. - Jensen A, Scholz CF, Kilian M. Re-evaluation of the taxonomy of the Mitis group of the genus Streptococcus based on whole
genome phylogenetic analyses, and proposed reclassification of Streptococcus dentisani as Streptococcus oralis subsp.
dentisani comb. nov., Streptococcus tigurinus as Streptococcus oralis subsp. tigurinus comb. nov., and Streptococcus
oligofermentans as a later synonym of Streptococcus cristatus. Int J Syst Evol Microbiol 2016; 66:4803-4820.
Positive for beta-N-acetylgalactosaminidase, beta-N-acetylglucosaminidase,
alpha-L-fucosidase, acid production from: arbutin, galactose, lactose,maltose,
trehalose and N-acetylglucosamine.
Negative for alkaline phosphatase, catalase, alpha-arabinosidase, esculin
hydrolysis, beta-fucosidase, alpha-galactosidase, alpha-glucosidase,
beta-glucosidase, oxidase, sialidase (neuraminidase), urea hydrolysis,
Voges-Proskauer test, acid productionfrom: amygdalin, arabinose, inulin, lactulose,
pullulan, mannitol, melibiose, melezitose, raffinose, rhamnose, ribose, sorbose,
sorbitol, tagatose, turanose and xylitol.
Variable for beta-galactosidase, arginine hydrolysis (strain NCTC 12479 is negative -
admin note).
alpha-L-fucosidase, acid production from: arbutin, galactose, lactose,maltose,
trehalose and N-acetylglucosamine.
Negative for alkaline phosphatase, catalase, alpha-arabinosidase, esculin
hydrolysis, beta-fucosidase, alpha-galactosidase, alpha-glucosidase,
beta-glucosidase, oxidase, sialidase (neuraminidase), urea hydrolysis,
Voges-Proskauer test, acid productionfrom: amygdalin, arabinose, inulin, lactulose,
pullulan, mannitol, melibiose, melezitose, raffinose, rhamnose, ribose, sorbose,
sorbitol, tagatose, turanose and xylitol.
Variable for beta-galactosidase, arginine hydrolysis (strain NCTC 12479 is negative -
admin note).

(c) Costin Stoica

| Antibiogram |
| Encyclopedia |
| Culture media |
| Biochemical tests |
| Stainings |
| Images |
| Movies |
| Articles |
| Identification |
| Software |
| R E G N U M PROKARYOTAE |

| Back |